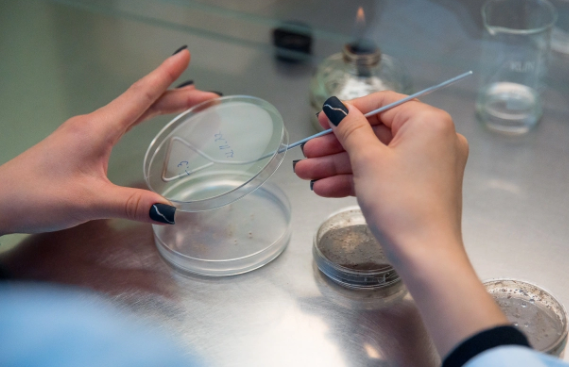

В Приморье специалисты не пустили на прилавки магазинов 50 тонн "тухляка"
Пробы были отобраны на складе временного хранения
 Самое популярное за 6 часов
Самое популярное за 6 часов

Пробы были отобраны на складе временного хранения
 Самое популярное за 6 часов
Самое популярное за 6 часов